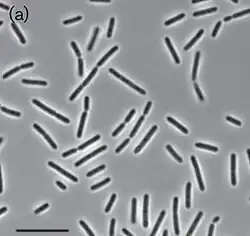

Paludibaculum
Paludibaculum es un género de bacterias gramnegativas de la familia Bryobacteraceae. Actualmente (2024) contiene una sola especie: Paludibaculum fermentans.[1] Fue descrito en el año 2014. Su etimología hace referencia a humedal. El nombre de la especie hace referencia a fermentación.[2] Es anaerobia facultativa e inmóvil. Crece de forma individual, en parejas o cadenas cortas. Tiene un tamaño de 0,4-0,6 μm de ancho por 2-9 μm de largo. Catalasa positiva y oxidasa negativa. Forma colonias circulares e incoloras. Temperatura de crecimiento entre 4-35 °C, óptima de 20-28 °C. Es sensible a ampicilina, cloranfenicol, estreptomicina, novobiocina y gentamicina. Resistente a lincomicina, kanamicina y neomicina. Tiene un genoma de 9,53 Mpb y un contenido de G+C de 60,5%.[3] Se ha aislado de humedales en la isla Valaam, Karelia, Rusia.
| Paludibaculum | ||
|---|---|---|
| ||
| Taxonomía | ||
| Dominio: | Bacteria | |
| Filo: | Acidobacteriota | |
| Clase: | Terriglobia | |
| Orden: | Bryobacterales | |
| Familia: | Bryobacteraceae | |
| Género: | Paludibaculum | |
| Especie: | Paludibaculum fermentans | |
Referencias
- «Genus: Paludibaculum». lpsn.dsmz.de (en inglés). Consultado el 10 de enero de 2024.
- Kulichevskaya, Irina S.; Suzina, Natalia E.; Rijpstra, W. Irene C.; Damsté, Jaap S. Sinninghe; Dedysh, Svetlana N. (2014-08). «Paludibaculum fermentans gen. nov., sp. nov., a facultative anaerobe capable of dissimilatory iron reduction from subdivision 3 of the Acidobacteria». International Journal of Systematic and Evolutionary Microbiology 64 (Pt 8): 2857-2864. ISSN 1466-5034. PMID 24867171. doi:10.1099/ijs.0.066175-0. Consultado el 18 de noviembre de 2023.
- Dedysh, Svetlana N.; Beletsky, Alexey V.; Kulichevskaya, Irina S.; Mardanov, Andrey V.; Ravin, Nikolai V. (7 de enero de 2021). «Complete Genome Sequence of Paludibaculum fermentans P105T, a Facultatively Anaerobic Acidobacterium Capable of Dissimilatory Fe(III) Reduction». Microbiology Resource Announcements 10 (1): e01313-20. ISSN 2576-098X. PMC 8407742. PMID 33414319. doi:10.1128/MRA.01313-20. Consultado el 18 de noviembre de 2023.